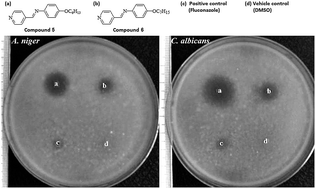

Otomycosis is a superficial infection of the ear caused by fungi. The disease may occur in the pinna, external auditory canal and tympanic membrane of humans and animals. Aspergillus niger and Candida albicans are the most prevalent fungal species responsible for otomycosis. In our study, the potential antifungal properties of a series of Schiff bases was examined. The synthesized compounds (1–14) were investigated for their minimum inhibitory concentration, minimum fungicidal concentration and zone of clearance against Aspergillus niger and Candida albicans. Compounds 5 and 6 with alkyl chain containing 6 or 7 carbon atoms exhibited an obvious fungicidal activity with the MIC/MFC ratio of 2. Zone of clearance study also demonstrated that both compounds 5 and 6 produced noticeable clear zones against the tested fungi as compared to fluconazole. The time-kill kinetic study showed that Candida albicans colonies were reduced by more than 3 logs after 24 h exposure to compound 5 at 4 and 8 × MIC levels. Both compounds 5 and 6 at a concentration of 50 μg mL−1 exhibited satisfactory cell viability towards human skin keratinocytes. Our results suggest that these compounds may be considered as potential drug candidates for the treatment of Aspergillus niger and Candida albicans ear infections.